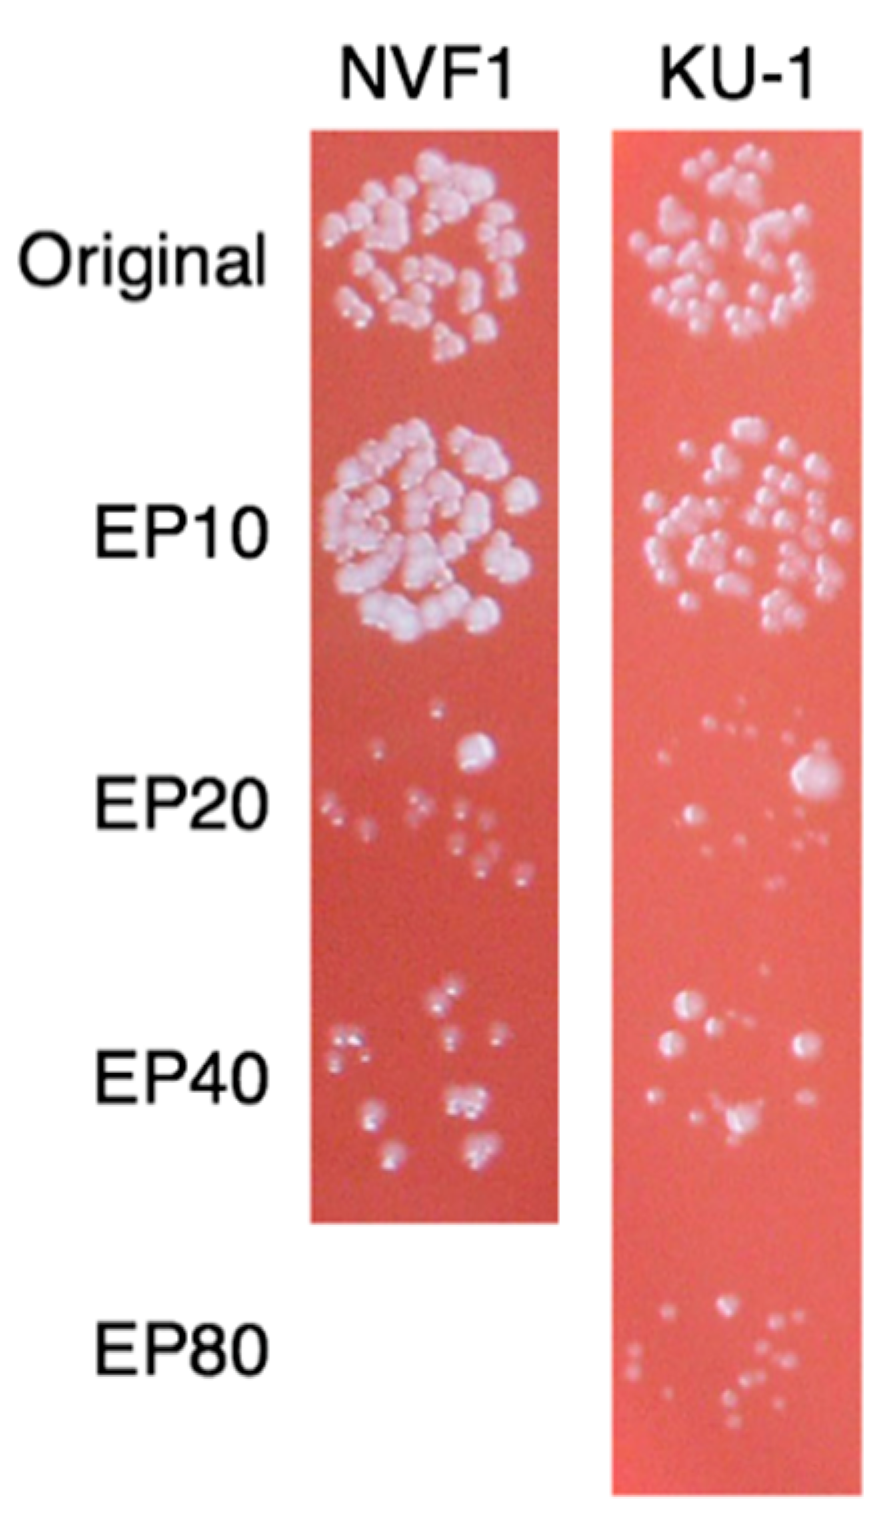

Virulence of Francisella tularensis Subspecies holarctica Biovar japonica and Phenotypic Change during Serial Passages on Artificial Media
Abstract
1. Introduction
2. Materials and Methods
2.1. Bacteria Culture
2.2. Animal Experiments
2.3. Quantification of Bacterial Burden
2.4. Serological Tests
2.5. Determination of Bacterial Growth Curves in CDM Broth
2.6. Intracellular Growth Ability of Bacteria in J774.1 Cells
2.7. Bacterial Viability after Hydrogen Peroxide (H2O2) Treatment
2.8. Sodium Dodecyl Sulfate Poly Acrylamide Gel Electrophoresis (SDS-PAGE) and Western Blotting
2.9. Minimum Inhibitory Concentration (MIC) against Antibiotics
2.10. Variable Number of Tandem Repeat (VNTR) Analysis
2.11. Statistical Analysis
3. Results
3.1. Virulence of Wild-type F. tularensis Subspecies Holarctica Biovar Japonica
3.1.1. Virulence of NVF1 and KU-1 Strains in Mice
3.1.2. Virulence of NVF1 Strain in Rats
3.2. Phenotype of Variants Passaged on Artificial Media
3.2.1. Colony Morphology and Growth Rate
3.2.2. Intracellular Growth of the Passaged Variants in J774.1 Cells
3.2.3. Virulence of the Passaged Variants in Mice
3.2.4. H2O2 Resistance of the Passaged Variants
3.2.5. Antigenic Changes on the Passaged Variants
3.2.6. Susceptibility of the Passaged Variants to Antibiotics
3.2.7. VNTR Profile
4. Discussion
5. Conclusions
Author Contributions
Funding
Acknowledgments
Conflicts of Interest
References
- Ellis, J.; Oyston, P.C.; Green, M.; Titball, R.W. Tularemia. Clin. Microbiol. Rev. 2002, 15, 631–646. [Google Scholar] [CrossRef] [PubMed]
- Hopla, C.E. The ecology of tularemia. Adv. Vet. Sci. Comp. Med. 1974, 18, 25–53. [Google Scholar] [PubMed]
- Eden, J.S.; Rose, K.; Ng, J.; Shi, M.; Wang, Q.; Sintchenko, V.; Holmes, E.C. Francisella tularensis ssp. holarctica in ringtail possums, australia. Emerg. Infect. Dis. 2017, 23, 1198–1201. [Google Scholar] [CrossRef] [PubMed]
- Olsufjev, N.G.; Meshcheryakova, I.S. Subspecific taxonomy of Francisella tularensis McCoy and Chapin 1912. Int. J. Syst. Bacteriol. 1983, 33, 872–874. [Google Scholar] [CrossRef]
- Vogler, A.J.; Birdsell, D.; Price, L.B.; Bowers, J.R.; Beckstrom-Sternberg, S.M.; Auerbach, R.K.; Beckstrom-Sternberg, J.S.; Johansson, A.; Clare, A.; Buchhagen, J.L.; et al. Phylogeography of Francisella tularensis: Global expansion of a highly fit clone. J. Bacteriol. 2009, 191, 2474–2484. [Google Scholar] [CrossRef]
- Kilic, S.; Celebi, B.; Acar, B.; Atas, M. In vitro susceptibility of isolates of Francisella tularensis from turkey. Scand. J. Infect. Dis. 2013, 45, 337–341. [Google Scholar] [CrossRef]
- Wang, Y.; Peng, Y.; Hai, R.; Xia, L.; Li, H.; Zhang, Z.; Cai, H.; Liang, Y.; Shen, X.; Yu, D.; et al. Diversity of Francisella tularensis subsp. holarctica lineages, China. Emerg. Infect. Dis. 2014, 20, 1191–1194. [Google Scholar]
- Johansson, A.; Farlow, J.; Larsson, P.; Dukerich, M.; Chambers, E.; Bystrom, M.; Fox, J.; Chu, M.; Forsman, M.; Sjostedt, A.; et al. Worldwide genetic relationships among Francisella tularensis isolates determined by multiple-locus variable-number tandem repeat analysis. J. Bacteriol. 2004, 186, 5808–5818. [Google Scholar] [CrossRef]
- Broekhuijsen, M.; Larsson, P.; Johansson, A.; Bystrom, M.; Eriksson, U.; Larsson, E.; Prior, R.G.; Sjostedt, A.; Titball, R.W.; Forsman, M. Genome-wide DNA microarray analysis of Francisella tularensis strains demonstrates extensive genetic conservation within the species but identifies regions that are unique to the highly virulent F. tularensis subsp. tularensis. J. Clin. Microbiol. 2003, 41, 2924–2931. [Google Scholar] [CrossRef]
- Johansson, A.; Ibrahim, A.; Goransson, I.; Eriksson, U.; Gurycova, D.; Clarridge, J.E., 3rd; Sjostedt, A. Evaluation of pcr-based methods for discrimination of Francisella species and subspecies and development of a specific pcr that distinguishes the two major subspecies of Francisella tularensis. J. Clin. Microbiol. 2000, 38, 4180–4185. [Google Scholar] [CrossRef]
- Ohara, H.; Ichikawa, K. The distribution of yato-byo and its clinical observations. Ann. Rep. Ohara Hosp. 1962, 11, 1–22. (In Japanese) [Google Scholar]
- Ohara, Y.; Sato, T.; Homma, M. Epidemiological analysis of tularemia in Japan (yato-byo). FEMS Immunol. Med. Microbiol. 1996, 13, 185–189. [Google Scholar] [CrossRef] [PubMed]
- Fujita, H. Short historical review of the isolates of tularemia agent in the early years of tularemia research in Japan with list of stock cultures of Francisella tularensis and other selected species in Ohara research laboratory. Ann. Rep. Ohara Hosp. 1994, 37, 5–12. (In Japanese) [Google Scholar]
- Sato, T. Memoris of tularemia research at the Ohara research laboratory for the past 70 years with special reference to the studies on isolation, culture, and virulence of tularemia agent. Ann. Rep. Ohara Hosp. 1994, 37, 1–4. [Google Scholar]
- Hotta, A.; Fujita, O.; Uda, A.; Yamamoto, Y.; Sharma, N.; Tanabayashi, K.; Yamada, A.; Morikawa, S. Virulence of representative Japanese Francisella tularensis and immunologic consequence of infection in mice. Microbiol. Immunol. 2016, 60, 168–176. [Google Scholar] [CrossRef] [PubMed]
- Hotta, A.; Fujita, O.; Uda, A.; Sharma, N.; Tanabayashi, K.; Yamamoto, Y.; Yamada, A.; Morikawa, S. In vitro antibiotic susceptibility of Francisella tularensis isolates from Japan. Jpn. J. Infect. Dis. 2013, 66, 534–536. [Google Scholar] [CrossRef]
- Fujita, O.; Uda, A.; Hotta, A.; Okutani, A.; Inoue, S.; Tanabayashi, K.; Yamada, A. Genetic diversity of Francisella tularensis subspecies holarctica strains isolated in Japan. Microbiol. Immunol. 2008, 52, 270–276. [Google Scholar] [CrossRef]
- Cowley, S.C.; Myltseva, S.V.; Nano, F.E. Phase variation in Francisella tularensis affecting intracellular growth, lipopolysaccharide antigenicity and nitric oxide production. Mol. Microbiol. 1996, 20, 867–874. [Google Scholar] [CrossRef]
- Soni, S.; Ernst, R.K.; Muszynski, A.; Mohapatra, N.P.; Perry, M.B.; Vinogradov, E.; Carlson, R.W.; Gunn, J.S. Francisella tularensis blue-gray phase variation involves structural modifications of lipopolysaccharide o-antigen, core and lipid a and affects intramacrophage survival and vaccine efficacy. Front. Microbiol. 2010, 1, 129. [Google Scholar] [CrossRef]
- Holland, K.M.; Rosa, S.J.; Kristjansdottir, K.; Wolfgeher, D.; Franz, B.J.; Zarrella, T.M.; Kumar, S.; Sunagar, R.; Singh, A.; Bakshi, C.S.; et al. Differential growth of Francisella tularensis, which alters expression of virulence factors, dominant antigens, and surface-carbohydrate synthases, governs the apparent virulence of ft schus4 to immunized animals. Front. Microbiol. 2017, 8, 1158. [Google Scholar] [CrossRef]
- Lindgren, M.; Tancred, L.; Golovliov, I.; Conlan, W.; Twine, S.M.; Sjostedt, A. Identification of mechanisms for attenuation of the FSC043 mutant of Francisella tularensis Schu S4. Infect. Immun. 2014, 82, 3622–3635. [Google Scholar] [CrossRef] [PubMed]
- Sjodin, A.; Svensson, K.; Lindgren, M.; Forsman, M.; Larsson, P. Whole-genome sequencing reveals distinct mutational patterns in closely related laboratory and naturally propagated Francisella tularensis strains. PLoS ONE 2010, 5, e11556. [Google Scholar] [CrossRef] [PubMed]
- Molins, C.R.; Delorey, M.J.; Yockey, B.M.; Young, J.W.; Belisle, J.T.; Schriefer, M.E.; Petersen, J.M. Virulence difference between the prototypic schu s4 strain (a1a) and Francisella tularensis A1a, A1b, A2 and type B strains in a murine model of infection. BMC Infect. Dis. 2014, 14, 67. [Google Scholar] [CrossRef] [PubMed]
- Hotta, A.; Tanabayashi, K.; Fujita, O.; Shindo, J.; Park, C.H.; Kudo, N.; Hatai, H.; Oyamada, T.; Yamamoto, Y.; Takano, A.; et al. Survey of Francisella tularensis in wild animals in Japan in areas where tularemia is endemic. Jpn. J. Infect. Dis. 2016, 69, 431–434. [Google Scholar] [CrossRef] [PubMed]
- Park, C.H.; Nakanishi, A.; Hatai, H.; Kojima, D.; Oyamada, T.; Sato, H.; Kudo, N.; Shindo, J.; Fujita, O.; Hotta, A.; et al. Pathological and microbiological studies of Japanese hare (lepus brachyurus angustidens) naturally infected with Francisella tularensis subsp. holarctica. J. Vet. Med. Sci. 2009, 71, 1629–1635. [Google Scholar] [CrossRef] [PubMed]
- Sato, T.; Ohara, S. On a long term preservation of Francisella tularensis in freeze state-report 1. Ann. Rep. Ohara Hosp. 1983, 26, 1–4. [Google Scholar]
- Sharma, N.; Hotta, A.; Yamamoto, Y.; Fujita, O.; Uda, A.; Morikawa, S.; Yamada, A.; Tanabayashi, K. Detection of Francisella tularensis-specific antibodies in patients with tularemia by a novel competitive enzyme-linked immunosorbent assay. Clin. Vaccine Immunol. 2013, 20, 9–16. [Google Scholar] [CrossRef]
- Lindemann, S.R.; McLendon, M.K.; Apicella, M.A.; Jones, B.D. An in vitro model system used to study adherence and invasion of Francisella tularensis live vaccine strain in nonphagocytic cells. Infect. Immun. 2007, 75, 3178–3182. [Google Scholar] [CrossRef]
- Lindgren, H.; Honn, M.; Salomonsson, E.; Kuoppa, K.; Forsberg, A.; Sjostedt, A. Iron content differs between Francisella tularensis subspecies tularensis and subspecies holarctica strains and correlates to their susceptibility to h(2)o(2)-induced killing. Infect. Immun. 2011, 79, 1218–1224. [Google Scholar] [CrossRef][Green Version]
- Barker, J.H.; Kaufman, J.W.; Apicella, M.A.; Weiss, J.P. Evidence suggesting that Francisella tularensis o-antigen capsule contains a lipid a-like molecule that is structurally distinct from the more abundant free lipid a. PLoS ONE 2016, 11, e0157842. [Google Scholar] [CrossRef]
- Hotta, A.; Uda, A.; Fujita, O.; Tanabayashi, K.; Yamada, A. Preparation of monoclonal antibodies for detection and identification of Francisella tularensis. Clin. Vaccine Immunol. 2007, 14, 81–84. [Google Scholar] [CrossRef] [PubMed]
- Caspar, Y.; Maurin, M. Francisella tularensis susceptibility to antibiotics: A comprehensive review of the data obtained in vitro and in animal models. Front. Cell Infect. Microbiol. 2017, 7, 122. [Google Scholar] [CrossRef] [PubMed]
- Reed, L.J.; Muench, H. A simple method of estimating fifty percent endpoints. Am. J. Epidemiol. 1938, 27, 493–497. [Google Scholar] [CrossRef]
- Fujita, O.; Hotta, A.; Uda, A.; Yamamoto, Y.; Fujita, H.; Shinya, F.; Asano, S.; Morikawa, S.; Tanabayashi, K.; Yamada, A. Identification of the source of Francisella tularensis infection by multiple-locus variable-number tandem repeat analysis. Jpn. J. Infect. Dis. 2013, 66, 543–545. [Google Scholar] [CrossRef]
- Fortier, A.H.; Slayter, M.V.; Ziemba, R.; Meltzer, M.S.; Nacy, C.A. Live vaccine strain of Francisella tularensis: Infection and immunity in mice. Infect. Immun. 1991, 59, 2922–2928. [Google Scholar] [CrossRef]
- Chen, W.; Shen, H.; Webb, A.; KuoLee, R.; Conlan, J.W. Tularemia in BALB/c and C57BL/6 mice vaccinated with Francisella tularensis LVS and challenged intradermally, or by aerosol with virulent isolates of the pathogen: Protection varies depending on pathogen virulence, route of exposure, and host genetic background. Vaccine 2003, 21, 3690–3700. [Google Scholar]
- Molins, C.R.; Delorey, M.J.; Yockey, B.M.; Young, J.W.; Sheldon, S.W.; Reese, S.M.; Schriefer, M.E.; Petersen, J.M. Virulence differences among Francisella tularensis subsp. tularensis clades in mice. PLoS ONE 2010, 5, e10205. [Google Scholar]
- Raymond, C.R.; Conlan, J.W. Differential susceptibility of sprague-dawley and fischer 344 rats to infection by Francisella tularensis. Microb. Pathog. 2009, 46, 231–234. [Google Scholar] [CrossRef]
- Kreizinger, Z.; Erdelyi, K.; Felde, O.; Fabbi, M.; Sulyok, K.M.; Magyar, T.; Gyuranecz, M. Comparison of virulence of Francisella tularensis ssp. holarctica genotypes b.12 and b.FTNf002-00. BMC Vet. Res. 2017, 13, 46. [Google Scholar]
- Conlan, J.W.; Chen, W.; Bosio, C.M.; Cowley, S.C.; Elkins, K.L. Infection of mice with Francisella as an immunological model. Curr. Protoc. Immunol. 2011, 93, 19.14.1–19.14.16. [Google Scholar]
- Rakhimova, E.; Munder, A.; Wiehlmann, L.; Bredenbruch, F.; Tummler, B. Fitness of isogenic colony morphology variants of pseudomonas aeruginosa in murine airway infection. PLoS ONE 2008, 3, e1685. [Google Scholar] [CrossRef] [PubMed]
- Phillips, N.J.; Schilling, B.; McLendon, M.K.; Apicella, M.A.; Gibson, B.W. Novel modification of lipid a of Francisella tularensis. Infect. Immun. 2004, 72, 5340–5348. [Google Scholar] [CrossRef] [PubMed]
- Vinogradov, E.; Perry, M.B.; Conlan, J.W. Structural analysis of Francisella tularensis lipopolysaccharide. Eur. J. Biochem. 2002, 269, 6112–6118. [Google Scholar] [CrossRef] [PubMed]
- Schilling, B.; McLendon, M.K.; Phillips, N.J.; Apicella, M.A.; Gibson, B.W. Characterization of lipid a acylation patterns in Francisella tularensis, Francisella novicida, and Francisella philomiragia using multiple-stage mass spectrometry and matrix-assisted laser desorption/ionization on an intermediate vacuum source linear ion trap. Anal. Chem. 2007, 79, 1034–1042. [Google Scholar]
- Stefanetti, G.; Okan, N.; Fink, A.; Gardner, E.; Kasper, D.L. Glycoconjugate vaccine using a genetically modified o antigen induces protective antibodies to Francisella tularensis. Proc. Natl. Acad. Sci. USA 2019, 116, 7062–7070. [Google Scholar] [CrossRef]
- Okan, N.A.; Kasper, D.L. The atypical lipopolysaccharide of francisella. Carbohydr. Res. 2013, 378, 79–83. [Google Scholar] [CrossRef] [PubMed]
- Wang, X.; Ribeiro, A.A.; Guan, Z.; Abraham, S.N.; Raetz, C.R. Attenuated virulence of a Francisella mutant lacking the lipid a 4′-phosphatase. Proc. Natl. Acad. Sci. USA 2007, 104, 4136–4141. [Google Scholar] [CrossRef]
- Wang, X.; Ribeiro, A.A.; Guan, Z.; Raetz, C.R. Identification of undecaprenyl phosphate-beta-d-galactosamine in Francisella novicida and its function in lipid a modification. Biochemistry 2009, 48, 1162–1172. [Google Scholar] [CrossRef]
- Raetz, C.R.; Reynolds, C.M.; Trent, M.S.; Bishop, R.E. Lipid a modification systems in gram-negative bacteria. Annu. Rev. Biochem. 2007, 76, 295–329. [Google Scholar] [CrossRef]
- Antunes, N.T.; Frase, H.; Toth, M.; Vakulenko, S.B. The class a beta-lactamase FTU-1 is native to Francisella tularensis. Antimicrob. Agents Chemother. 2012, 56, 666–671. [Google Scholar] [CrossRef]
- Bina, X.R.; Wang, C.; Miller, M.A.; Bina, J.E. The Bla2 beta-lactamase from the live-vaccine strain of Francisella tularensis encodes a functional protein that is only active against penicillin-class beta-lactam antibiotics. Arch. Microbiol. 2006, 186, 219–228. [Google Scholar] [CrossRef] [PubMed]
- Hotta, A.; Fujita, O.; Tanabayashi, K.; Uda, A.; Shindo, J.; Park, C.-H.; Sato, H.; Suzuki, M.; Morikawa, S.; Maeda, K. Complete genome sequences of two strains of Francisella tularensis subspecies holarctica bv. Japonica. Microbiol. Resour. Announc. 2020, 9, e01127-20. [Google Scholar] [PubMed]
- Dwibedi, C.; Larsson, P.; Ahlinder, J.; Lindgren, P.; Myrtennas, K.; Granberg, M.; Larsson, E.; Ohrman, C.; Sjodin, A.; Stenberg, P.; et al. Biological amplification of low frequency mutations unravels laboratory culture history of the bio-threat agent Francisella tularensis. Forensic Sci. Int. Genet. 2019, 45, 102230. [Google Scholar] [CrossRef]
- Johansson, A.; Goransson, I.; Larsson, P.; Sjostedt, A. Extensive allelic variation among Francisella tularensis strains in a short-sequence tandem repeat region. J. Clin. Microbiol. 2001, 39, 3140–3146. [Google Scholar] [CrossRef]
- Muller, W.; Hotzel, H.; Otto, P.; Karger, A.; Bettin, B.; Bocklisch, H.; Braune, S.; Eskens, U.; Hormansdorfer, S.; Konrad, R.; et al. German Francisella tularensis isolates from european brown hares (lepus europaeus) reveal genetic and phenotypic diversity. BMC Microbiol. 2013, 13, 61. [Google Scholar] [CrossRef] [PubMed]

| Route | Rat Strain | Challenge Dose (Colony-Forming Unit) | No. of Survivors/Total | Day of Death (Day Post Inoculation) | Initial Day of Body Weight Loss (Day Post Inoculation) |
|---|---|---|---|---|---|
| i.d. | F344 | 3.2 × 102 | 4/4 | − | − |
| SD | 3.2 × 102 | 4/4 | − | − | |
| i.p. | F344 | 3.8 × 101 | 1/4 | 4, 5, 8 | 3, 4, 4 |
| 1.1 × 102 | 1/4 | 4, 7, 10 | 4, 4, 5 | ||
| 1.1 × 103 | 1/4 | 4, 4, 4 | 3, 3, 3, 4 | ||
| 3.8 × 104 | 0/4 | 3, 3, 3, 5 | 2, 2, 2, 2 | ||
| SD | 1.4 × 103 | 3/5 | 4, 8 | 3, 4, 4, 4 | |
| 1.4 × 104 | 3/4 | 4 | 2, 3, 4, 8 | ||
| 1.4 × 105 | 1/4 | 3, 4, 4 | 2, 2, 2, 4 | ||
| 1.1 × 106 | 0/3 | 3, 3, 3 | 2, 2, 2 | ||
| 1.1 × 107 | 1/4 | 2, 3, 3 | 1, 2, 2, 3 |
| Antibiotic | MIC of KU-1 * | MIC Range Among Japanese Strains [16] | ||||
|---|---|---|---|---|---|---|
| Original | EP20 | EP40 | EP80 | CP50 | ||
| Aztreonam | ≥256 | ≥256 | ≥256 | 8 | ≥256 | 0.75 to ≥256 |
| Cefotaxime | ≥256 | ≥256 | ≥256 | 0.38 | ≥256 | 0.047 to ≥256 |
| Cefoxitin | ≥256 | ≥256 | 2 | 2 | ≥256 | 0.25 to ≥256 |
| Ceftriaxone | ≥32 | ≥32 | 0.25 | 0.25 | ≥32 | 0.047 to ≥32 |
| Cefuroxime | ≥256 | ≥256 | 12 | 12 | ≥256 | 0.5 to ≥256 |
| Imipenem | ≥32 | ≥32 | 0.5 | 0.5 | ≥32 | 0.047 to ≥32 |
Publisher’s Note: MDPI stays neutral with regard to jurisdictional claims in published maps and institutional affiliations. |
© 2020 by the authors. Licensee MDPI, Basel, Switzerland. This article is an open access article distributed under the terms and conditions of the Creative Commons Attribution (CC BY) license (http://creativecommons.org/licenses/by/4.0/).
Share and Cite
Hotta, A.; Sharma, N.; Fujita, O.; Uda, A.; Tanabayashi, K.; Tian, D.; Yamada, A.; Morikawa, S.; Maeda, K. Virulence of Francisella tularensis Subspecies holarctica Biovar japonica and Phenotypic Change during Serial Passages on Artificial Media. Microorganisms 2020, 8, 1881. https://doi.org/10.3390/microorganisms8121881
Hotta A, Sharma N, Fujita O, Uda A, Tanabayashi K, Tian D, Yamada A, Morikawa S, Maeda K. Virulence of Francisella tularensis Subspecies holarctica Biovar japonica and Phenotypic Change during Serial Passages on Artificial Media. Microorganisms. 2020; 8(12):1881. https://doi.org/10.3390/microorganisms8121881
Chicago/Turabian StyleHotta, Akitoyo, Neekun Sharma, Osamu Fujita, Akihiko Uda, Kiyoshi Tanabayashi, Deyu Tian, Akio Yamada, Shigeru Morikawa, and Ken Maeda. 2020. "Virulence of Francisella tularensis Subspecies holarctica Biovar japonica and Phenotypic Change during Serial Passages on Artificial Media" Microorganisms 8, no. 12: 1881. https://doi.org/10.3390/microorganisms8121881
APA StyleHotta, A., Sharma, N., Fujita, O., Uda, A., Tanabayashi, K., Tian, D., Yamada, A., Morikawa, S., & Maeda, K. (2020). Virulence of Francisella tularensis Subspecies holarctica Biovar japonica and Phenotypic Change during Serial Passages on Artificial Media. Microorganisms, 8(12), 1881. https://doi.org/10.3390/microorganisms8121881

